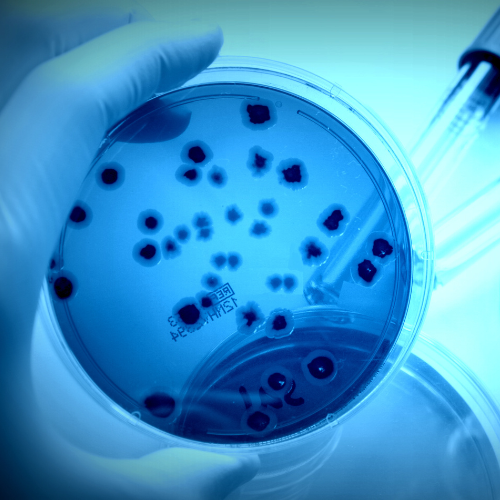
pruebas-de-microbiologia-cerca-de-mi.png

¿Buscaste pruebas de Microbiología cerca de mí? En Laboratorios Moreno trabajamos con químicos profesionales desde 2006 y nos encontramos en constante crecimiento con el objetivo de ofrecerte el mejor servicio disponible. Ofrecemos servicios de análisis clínicos de alta calidad para tu tranquilidad. Contáctanos de inmediato.
Reserva una consulta personalizada y pregunta por las pruebas de Microbiología cerca de mí, no esperes y contáctanos ahora.
Al llamar al teléfono que aparece en esta página podrás contactarnos y preguntar por las pruebas de Microbiología cerca de mí. Agenda tu cita de inmediato.
Contáctanos a través de una llamada o whatsapp al:
• (998) 341 5792
Correo Electrónico
recepcion@laboratoriosmoreno.com.mx
DIRECCIÓN
Av. Kabah Reg. 230 Mza. 53 Lt. 16, 77516 Cancún, Q.R.
Recibe una atención de alta calidad de mano de un Laboratorio especialista, pregunta por las pruebas de Microbiología cerca de mí, llámanos hoy.
Encuentra una excelente opción en tu búsqueda de pruebas de Microbiología cerca de mí, llámanos y conoce los servicios en los que Laboratorios Moreno se especializa.
Da clic en el botón de WhatsApp para recibir más información sobre una de las mejores opciones para tu búsqueda de pruebas de Microbiología cerca de mí.